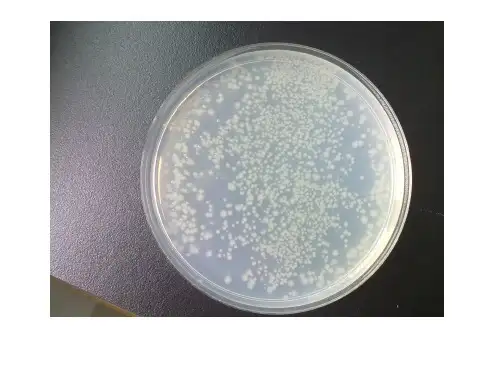

实验八、转基因生物的GUS检测资料讲解
- 格式:ppt
- 大小:1.82 MB
- 文档页数:14

含GUS报告基因的转GUS染色一、原理Gus (b-glucuronidase)基因作为一种报告基因,在植物遗传转化研究中有广泛的用途。
Gus基因来自于大肠杆菌,编码b,葡聚糖苷酶(一种水解酶),可催化底物5,溴,4,氯,3,吲哚葡聚糖醛酸苷(5,bromo-4-chloro-3-indolyl-glucronide,缩写为X,Gluc)分解,产生肉眼可见的深兰色化合物,借此用来观察转基因植物中外源基因的表达情况,鉴定转基因植株。
二、目的了解转基因植物中基因表达的器官、组织和细胞的特异性,掌握Gus报告基因表达的组织化学定位的方法。
三、材料与试剂1、转基因植物的组织、器官、种胚或幼苗。
t2、同种非转化植物的组织、器官、种胚或幼苗。
3、50mM磷酸缓冲液(pH 7.0)。
4、染色液:100mM K3[Fe(CN)6], 100mM K4[Fe(CN)6] 10mMNa2EDTA, 0.001% (v/v) triton X-100, 20%甲醇,0.5mg/ml X-Gluc, 磷酸缓冲液(50mM, pH 7.0)。
5、70,乙醇。
四、操作步骤1、将准备好的材料冲洗干净,用吸水纸吸干,浸在上述染色液中37?恒温条件下保温过夜。
2、转入70,乙醇中脱色2,3次,去除叶绿素,至阴性对照材料呈白色时为止。
3、肉眼或显微镜下观察,白色背景上的兰小点即为Gus基因表达的位点。
4、83,、95,、100,乙醇中脱水,二甲苯透明,石蜡包埋。
5、常规石蜡切片法切片,番红染色。
6、显微镜下观察、拍照。
五、说明1、要设立严格的阴性对照,即用同样的未转化的材料按相同的方法同时进行染色。
如阴性对照显示兰色,其原因可能是:A)材料和试剂被细菌感染;B)保温时间过长。
2、染色液中的甲醇可抑制细菌生长,长时间染色可加入0.02% NaN3或100mg/ml的氯霉素,短时间染色也可以不加。
3、叶绿体含量高的材料染色后要进行脱色。

GUS报告基因范文GUS报告基因是一种用于筛选转基因植物的报告基因。
它在植物细胞内表达的酵素β-葡萄糖苷酶(β-Glucuronidase,GUS),能够将葡萄糖醛酸(X-Gluc)转化为蓝色产物。
通过观察和分析植物组织的GUS活性,可以判断是否发生了基因转化。
下面将详细介绍GUS报告基因的特点、应用以及实验方法。
1.GUS报告基因的特点(1)GUS基因来自于大肠杆菌,它很少在真核生物中表达,因此不会对植物正常生长发育产生影响。
(2)GUS基因编码的酵素活性能够方便、快速地用染色剂标记出来,实验结果直观可见。
(3)转GUS基因的步骤相对简单,转化率较高,且不需要使用昂贵的设备。
2.GUS报告基因的应用(1)植物转基因筛选:通过观察和分析转基因植物的GUS活性,可以确定哪些植株成功地转化了外源基因。
(2)基因调控研究:GUS报告基因可以用来研究目的基因的表达调控机制,例如在转基因植物中瞬时表达GUS基因,观察其在各种组织和发育阶段的表达情况,可以推测目的基因的启动子活性。
(3)信号传导途径研究:通过构建GUS基因的操纵,可以研究植物信号传导途径中特定基因的表达情况,进而了解信号传导途径的效率和调节机制。
3.实验方法以下是GUS报告基因实验的一般步骤:(1)构建GUS载体:将GUS基因与适合的植物表达载体进行连接,形成GUS转化载体。
(2)遗传转化:将GUS转化载体导入要进行转基因植物研究的植物细胞中,使用适当的生物技术方法(如冲击法、农杆菌介导法)实现遗传转化。
(3)植物筛选:选择经过转化的植株进行分析,通常可以通过PCR、Southern blot、Western blot等技术检测GUS基因的存在。
(4)组织切片染色:收集不同部位的植物组织,例如叶片、根、花等,制作切片。
使用X-Gluc作为底物加入切片中,观察蓝色染色产物的形成。
(5)定量分析:通过测定GUS活性,使用亲合素、含有底物的液体培养基等方法,可以 quantitatively 地测定GUS酶活性。

gus 基因PCR 反应程序: 94℃预变性5 min 94℃变性1 min58℃退火1 min 30个循环 72℃延伸2min 72℃延伸7 mingus 基因引物序列为:5’GCTATACGCCTTTGAAGCC 3’和5’TTGACTGCCTCTTCGCTGTA 3’GUS 染色母液:X-Gluc 由DMSO 溶解,贮存浓度为l0mg/mL,于-20°C 保存。
GUS 染液:500mg/L X-Gluc, 0.1mol/L K3Fe(CN)6,0.lmol/L K4Fe(CN)6,0.0lmol/L ,的配制方法:将7.800g NaH2PO4溶于水,定容至100ml●这是1ml的配方体系:终浓度药品分子量体积0.5M Na2EDTA 20ulTritonX-100 1ul1M 磷酸钠缓冲液(PH7.0) 100ul0.1M K3Fe(CN)6 5ul0.1M K4Fe(CN)6 5ul10mg/ml X-Gulc 200ul去离子水或无菌水669ul染液配方0.05M磷酸缓冲液 4.48ml 5mM铁氰化钾0.05ml, 5mM亚铁氰化钾0.05ml,Triton-100 0.01ml,水4.64ml,X-Gluc先溶于0.05ml DMF中,终浓度为0.5mg/ml37度染色过夜1.2染色步骤1)染色:加入适量配制好的GUS染液于24孔板的孔中,将待测样品浸到GUS染液中,将24孔板置于37℃保温箱中放置6h。
2)漂洗:先后用50%,70%,100%的乙醇漂洗样品,每次浸泡5分钟。
3)脱色:加入100%乙醇浸泡直至完全脱色。
4)记录:在体视显微镜下拍照记录。
2.GUS报导基因的定量检测GUS能与底物MUG(分子量352.3,4-甲基伞型酮-β-葡萄糖醛酸苷,4-methylumbelliferylβ-D-glucuronide)反应产生荧光物质MU(分子量198.2,4-甲基伞型酮,4-methylumbelliferone)。

转基因植株的GUS染色1、X-Gluc 母液:100 mg X-Gluc溶于5 ml DMF中;2、基液:50 mM PBS pH7.0(NaH2PO450 mM 0.78 g/100 ml, Na2HPO450 mM 1.791 g/100 ml)溶解EDTA·2Na(10 mM, 372 mg), Triton-100(0.1%,100 μl), 铁氢化钾(0.5 mM, 16.5 mg),亚铁氢化钾(0.5 mM, 21.1 mg)定容至100 ml;3、X-Gluc使用液:50 μl母液+950 μl基液,混匀备用,可存放于-20℃。
取合适大小的转基因苗浸入GUS染液中,37℃染色1-24小时直到染出理想效果;吸去反应液,乙醇梯度脱色。
体视镜观察并拍照。
这是转基因植株的染色,我想也可以用来做愈伤的染色。
GUS染色protocols2007-06-11 05:25Tissue for GUS staining was gently fixed by incubation in 90% acetone, on ice, for 15 to 20 min and then rinsed in 50 mM NaPO4, pH7.2, 0.5 mM K3Fe(CN)6, and 0.5 mM K4Fe(CN)6. The tissue was then placed in staining solution (50 mM NaPO4, pH 7.2, 2 mM X-gluc[Gold Biotechnology, St. Louis, MO], 0.5 mM K3Fe[CN]6, and 0.5 mMK4Fe[CN]6), vacuum infiltrated, and incubated at 37°C overnight. After staining, the tissue was processed through an ethanol series (30, 50, 70, 85, 95, 100, and 100%), with the 50% step of the series replaced by a 1 -hr formaldehyde-acetic acid fixation (50% ethanol, 5% acetic acid, and 3.7% formaldehyde). To prepare tissue for histological analysis, we passed tissue through a xylene series and embedded it in Paraplast (Sigma). Sections (10 μm) were cut from the embedded tissue, wax was removed by a brief incubation in xylene, and sections were mounted in Paraplast. Sections were visualized using dark-field illumination. (Leslie E. Sieburth et al Plant Cell, 1997, 9, 355-365)1. 染色材料在90%的丙酮中固定15-20min2. 漂洗后,加入GUS染液,抽气,37度过夜3. 乙醇脱色(30,50,70, 95, 100%的依次梯度)后,加入FAA固定液4. 包埋,按石蜡切片步骤进行二、GUS histochemical stainingStock50mM K3Fe(CN)6 0.82315 g/50 ml50mM K4Fe(CN)6 1.056 g/50 ml1M Na2HPO4 7.1 g/50 ml1M KH2PO4 6.8 g/50 ml0.5M Na2EDTA 18.612 g/ 100ml(直接加入 NaOH crystal,調pH = 8.0 )10﹪Triton X-100 1ml/10mlStaining solution(有毒,請戴手套操作)Stock final conc. 1M Na2HPO4 100mM phosphate buffer 0.64ml1M KH2PO4 0.36ml0.5M Na2EDTA 10mM 0.2ml50mM K3Fe(CN)6 0.5mM 0.1ml50mM K4Fe(CN)6 0.5mM 0.1ml10﹪Triton X-100 0.1﹪ 0.1mlMeOH(有毒) 10﹪ 1mlx-gluc 0.3﹪ 30mg以250μl DMSO(有機溶劑)溶解,加水至1mlTotal volume 10ml1. 剪取sample,將 staining solution 加入至可淹沒sample 為止2. 抽氣5min,37℃ incubate O/N3. 以70﹪ EtOH 洗掉葉綠素。

G U S染色一、原理Gus (b-glucuronidase)基因作为一种报告基因,在植物遗传转化研究中有广泛的用途。
Gu s基因来自于大肠杆菌,编码b-葡聚糖苷酶(一种水解酶),可催化底物5-溴-4-氯-3-吲哚葡聚糖醛酸苷(5-bromo-4-chloro-3-indolyl-glucronide,缩写为X-Gluc)分解,产生肉眼可见的深兰色化合物,借此用来观察转基因植物中外源基因的表达情况,鉴定转基因植株。
二、目的了解转基因植物中基因表达的器官、组织和细胞的特异性,掌握Gus报告基因表达的组织化学定位的方法。
三、材料与试剂1、转基因植物的组织、器官、种胚或幼苗。
t2、同种非转化植物的组织、器官、种胚或幼苗。
3、50mM磷酸缓冲液(pH 7.0)。
4、染色液:100mM K3[Fe(CN)6], 100mM K4[Fe(CN)6] 10mM Na2EDTA, 0.001% (v/v) tr iton X-100, 20%甲醇,0.5mg/ml X-Gluc, 磷酸缓冲液(50mM, pH 7.0)。
5、70%乙醇。
四、操作步骤1、将准备好的材料冲洗干净,用吸水纸吸干,浸在上述染色液中37℃恒温条件下保温过夜。
2、转入70%乙醇中脱色2-3次,去除叶绿素,至阴性对照材料呈白色时为止。
3、肉眼或显微镜下观察,白色背景上的兰小点即为Gus基因表达的位点。
4、83%、95%、100%乙醇中脱水,二甲苯透明,石蜡包埋。
5、常规石蜡切片法切片,番红染色。
6、显微镜下观察、拍照。
五、说明1、要设立严格的阴性对照,即用同样的未转化的材料按相同的方法同时进行染色。
如阴性对照显示兰色,其原因可能是:A)材料和试剂被细菌感染;B)保温时间过长。
2、染色液中的甲醇可抑制细菌生长,长时间染色可加入0.02% NaN3或100mg/ml的氯霉素,短时间染色也可以不加。
3、叶绿体含量高的材料染色后要进行脱色。

GUS活性的定量检测目的:定量检测转基因植株中报告基因GUS的表达水平用途:比较某个启动子在不同组织中的表达强度,比较不同启动子在同一组织中的表达强度。
试剂:①磷酸缓冲液母液:0.2M Na2HPO4:71.64g/L Na2HPO4·12H2O0.2M NaH2PO4:31.21g/L NaH2PO4·2H2O②GUS抽提液(1L):PH=7.00.2M Na2HPO4152.5mL0.2M NaH2PO497.5mL14.3M β-ME 700uLNa2-EDTA·2H2O 3.72gTriton-X 100 1mL③10mM 4-MUG(10×):105.6mg 4-MUG溶于30mL GUS抽提液中,4℃避光保存。
(注意:存放时间越久本底信号越强,尽量现配现用)。
④0.2M Na2CO3反应终止液(1L):21.2g Na2CO3溶于1000mL ddH2O。
⑤BSA母液(4ug/ul):40mgBSA溶于10mL ddH2O⑥4-MU母液(10mM):17.6mg 4-MU溶于10mL 0.2M Na2CO3中,4℃避光保存。
⑦Protein Assay Buffer(5×,Bio-Rad cat.no.500-0006):使用前要用ddH2O稀释成1×工作液仪器及用品:酶标仪TECAN Infinite M200酶标板(Nunclon 96 Flat Transparent和Greiner 96 Flat Black)操作步骤与注意事项:1.材料于液氮中研磨成粉末,取适量粉末加入3倍体积的GUS抽提液,充分混匀,置冰上。
(注意,尽量保证每个样品所取的粉末量都比较一致,这样抽提出来的总蛋白浓度比较接近,方便后续操作。
)2.10000g 4℃离心10min,上清液转移到新的1.5mL离心管,则得到总蛋白粗提液(可于4度短期保存或于-70℃长期保存;但不要存于-20℃,该温度下GUS不稳定)。

gus报告基因GUS报告基因。
GUS报告基因是一种用于植物基因表达研究的重要工具。
它是由β-葡萄糖苷酶(β-glucuronidase)基因构建而成,可以被广泛地应用于植物遗传转化和表达分析中。
GUS报告基因的研究对于理解植物基因表达及其调控机制具有重要意义。
首先,GUS报告基因可以用于植物遗传转化的研究。
通过将GUS报告基因导入植物细胞,可以观察到该基因在植物体内的表达情况。
这对于研究外源基因在植物中的表达特点以及转基因植物的遗传稳定性具有重要意义。
通过对GUS报告基因的研究,可以更好地了解植物转基因技术的应用前景及其潜在风险。
其次,GUS报告基因也可以用于植物基因表达分析。
通过将GUS报告基因与目标基因进行融合,可以观察到目标基因在植物体内的表达情况。
这对于研究目标基因在不同组织和发育阶段的表达模式,以及其受到外界环境因素影响的调控机制具有重要意义。
通过对GUS报告基因的研究,可以更好地了解植物基因表达调控的分子机制及其在植物生长发育过程中的作用。
此外,GUS报告基因还可以用于植物转基因技术的研究与应用。
通过对GUS报告基因的表达情况进行定量和定位分析,可以更好地评估转基因植物的表达效率和稳定性。
这对于改良转基因植物的遗传背景和表达性能具有重要意义。
通过对GUS报告基因的研究,可以更好地指导植物转基因技术的开发和应用,为农业生产和生物技术研究提供有力支持。
综上所述,GUS报告基因在植物基因表达研究中具有重要的应用价值。
通过对GUS报告基因的研究,可以更好地理解植物基因表达及其调控机制,促进植物遗传转化和基因功能研究的进展,为植物生物技术的发展和应用提供重要支持。
因此,对GUS报告基因的深入研究具有重要的理论和实际意义,值得进一步深入探讨和应用。

荧光光度计定量分析转化植株GUS基因稳定表达活性一、试剂准备:1.GUS提取缓冲液:●50mmol 磷酸钠(PH7.0)●10mmol EDTA●0.1% Triton X-100●0.1% Sarcosyl●10mmol/l β-巯基乙醇2.1mmol/L 4-MU(4-甲基伞形酮):称取19.82mg4-MU钠盐,用1ml乙醇溶解,dH2O定容至100ml。
4℃暗处可以贮存一个月。
贮存中有可能发生结晶。
3.反应缓冲液:GUS提取缓冲液中加入1mmol/l MUG(100ml 加入35.23mg),4℃可以保存2周。
4.考马新亮旒G250溶液:lOOmg考马斯亮蓝G250溶于50m1 95%乙醇中,加lOOml磷酸,dH2O定容至1L过滤后于4℃贮存。
二、操作步骤:新鲜的植物组织6US蛋白的提取:A.取0.1g叶片样品,用液氮研磨成粉。
B.2.加入3倍体积的提取缓冲液,研成匀浆。
C.3.4000rpm离心lOmin,收集上清液,于-20℃冰箱中保存备用。
GUS蛋白提取液蛋白含量测定:1.制作标准曲线:BSA母液(ml)H2O(ml)BSA浓度(ug/ml)0.25 4.75 1.250.5 4.5 2.51.0 4.0 5.01.5 3.5 7.52.03.0 10.02.5 2.5 12.55.0 0.0 25.0配制25ug/ml BSA母液:称取2.5mgBSA,加入0.5ml提取缓冲液,用H2O定容至lOOml。
按上表制作BSA梯度液。
从中取4ml加入lml考马斯亮蓝G-250溶液,混匀,室温下放置2min,测定595nm 的吸收值。
吸收值对蛋白浓度作图绘制标准曲线。
取植物材料GUS蛋白提取液20ul,加H2O至4ml,加入lml考马斯亮蓝,混匀,室温下放置2min。
测定595nm光吸收值根据标准曲线计算蛋白质含量。
GUS酶活反应:1. 将反应缓冲液于37℃预热。
2.取6支1.5ml离心管,各加入900ul反应终止液,编号。

gus染色原理Gus染色原理。
Gus染色是一种常用的生物学实验技术,主要用于检测β-葡萄糖苷酶(β-glucuronidase)的活性。
β-葡萄糖苷酶是一种水解酶,能够水解含有葡萄糖醛酸的底物。
在实验中,通过对含有β-葡萄糖苷酶的细胞或组织进行Gus染色,可以直观地观察到β-葡萄糖苷酶的活性分布情况,从而对生物学研究提供重要的信息。
Gus染色的原理主要包括底物、酶作用和染色三个步骤。
首先是选择合适的底物,通常使用5-溴-4-氯-3-吲哚基葡萄糖苷(X-Gluc)作为底物,它在β-葡萄糖苷酶的作用下会产生可染色的产物。
其次是酶作用,β-葡萄糖苷酶在底物的作用下水解产生的产物,这些产物会与染色剂发生化学反应,形成蓝色的沉淀物。
最后是染色,将样品浸泡在染色液中,待染色完成后观察样品的染色情况。
Gus染色的实验步骤相对简单,但在实验过程中仍需注意一些关键的技术细节。
首先是对样品的处理,样品的预处理对实验结果有着重要的影响。
其次是对底物和染色剂的选择,合适的底物和染色剂可以提高实验的准确性和可靠性。
最后是对实验条件的控制,包括温度、时间、pH值等因素的控制都会对实验结果产生影响。
Gus染色技术在生物学研究中有着广泛的应用,特别是在植物和微生物领域。
通过对植物组织进行Gus染色,可以观察到β-葡萄糖苷酶在不同组织和不同发育阶段的表达情况,从而研究植物的生长发育过程。
在微生物研究中,Gus染色也常用于检测转基因微生物中外源基因的表达情况,为基因功能研究提供重要的数据支持。
总的来说,Gus染色是一种简单而有效的生物学实验技术,通过对β-葡萄糖苷酶活性的检测,为生物学研究提供了重要的手段。
在实际应用中,我们需要充分理解其原理和操作技巧,才能更好地利用这一技术进行科学研究。
希望本文对Gus染色的原理有所帮助,谢谢阅读!。

1.GUS报告基因的定性检测GUS(β- 葡萄糖苷酸酶)能与显色底物X-gluc 反应,显现蓝色,因而可以通过组织化学染色定性研究GUS的表达水平和表达模式。
GUS 染色的稳定性好,组织定位精确,成为在植物中运用很广的报道基因。
gus基因是目前常用的一种报告基因,是β-D-葡萄糖苷酸酶(gus)基因,其表达产物β-葡萄糖苷酸酶(GUS)能催化裂解一系列的β-葡萄糖苷酸,它可以将5-溴-4-氯-3-吲哚-β-葡萄糖苷酸酯(X-Gluc)分解为蓝色的物质,也可以将4-甲基-伞形花酮-β-D-葡萄糖苷酯(4-MUG)分解为蓝色物质。
其检测方法简单、快速、灵敏、稳定,且背景活性低。
1.1 GUS染色底物的配制* 0.5M Na2HPO4配制方法:将17.907g Na2HPO4溶于水,定容至100ml。
0.5M NaH2PO4的配制方法:将7.800g NaH2PO4溶于水,定容至100ml。
实验步骤:1.将准备好的拟南芥植株放入小EP管中,加入染色液浸没试材,封好盖子;可用抽真空,5min,200mbr。
2.37℃培养箱中温育12h,或有蓝色出现,水中洗涤一次;3.将浸染过的试材转入70%(或95%乙醇)中脱色2-3次(除去叶绿素),每隔1小时更换一次脱色液,至阴性对照材料呈白色为止。
(漂洗:先后用50%,70%,100%的乙醇漂洗样品,每次浸泡5分钟。
脱色:加入100%乙醇浸泡直至完全脱色。
)4.立体显微镜观察拍照。
2.GUS报导基因的定量检测GUS 能与底物MUG(分子量352.3,4-甲基伞型酮-β-葡萄糖醛酸苷,4-methylumbelliferylβ-D-glucuronide)反应产生荧光物质MU(分子量198.2,4-甲基伞型酮,4-methylumbelliferone)。
MU的激发波长为365nm,发射波长为456nm,其含量可由荧光分光光度计测出。
因此,我们可以根据单位质量的植物总蛋白在单位时间内产生的荧光物质的多少来定量的检测GUS含量。
GUS 活性检测目的:通过Gus活性测定了解或研究Gus基因是否转化进入植物细胞;Gus基因在植物组织、细胞内的表达部位;Gus基因在植物细胞内瞬时表达量及稳定表达量;外源基因在植物细胞内的表达调控。
材料:转化的植物组织、器官、原生质体、种子的胚及萌发的幼苗等。
一、组织化学染色法试剂:(1)200mmol/L 磷酸钠缓冲液(pH7.0)制备方法:A液:称取NaH2PO4·2H2O3.12g溶于蒸馏水,定容至100ml。
B液:称取Na2HPO4·12H2O7.17g溶于蒸馏水,定容至100ml。
取100ml B液与40ml A液混合(混合后pH值约7.03),用NaH2PO4·2H2O 调至7.0。
(2)*说明:GUS活性的精确定位需要有亚铁离。
GUS酶水解其底物X-Gluc产生可溶性无色的吲哚基衍生物,它可扩散到其他部位,必须经氧化缩合成二聚体,才能形成不溶性的蓝色沉淀,二聚体化由氧化催化剂(如亚铁氰化钾、过氧化物酶或过氧化氢酶等)催化,若不加Fe2-,则仅形成可溶性中间产物而扩散,加亚铁氰化钾后因吲哚基二聚体化而不扩散,不溶性蓝色沉淀形成越快,GUS酶的定位越精确。
(3)FAA固定脱色液:5%甲醛,5%乙酸,5%乙醇。
材料准备:(1) 瞬时表达检测取浸染后1-5天的材料,稳定表达取转化后处理6周后的材料。
(2) 叶片、幼根等制成徒手切片(或剪成小块、小片)。
(3) 悬浮细胞、原生质体低速离收集,无菌等渗液洗涤。
(4) 清洁的愈伤组织可以直接使用直接染色法(1)将准备好的材料浸泡在染液中,于25-37℃保温1小时至过夜。
(2)叶片等绿色材料转入70%乙醇中脱色2-3次,到阴性对照材料呈白色。
(3)肉眼或显微镜下观察,白色背景上的蓝色小点即为Gus表达位点。
固定染色法(1)将材料浸入固定液中,必要时可抽真空1分钟,室温下轻摇30-60分钟。
(2)取出材料,用磷酸钠缓冲液漂洗3-4次。
一、实验原理:1、适宜的反应条件下,β- 葡萄糖苷酸酶(GUS)可将X-Gluc水解成蓝色物质,因此具有GUS活性的部位或位点呈现蓝色或蓝色斑点,可用肉眼或显微镜观察到。
二、实验步骤:1、将准备好的拟南芥植株放入小EP管中,加入染色液浸没试材,封好盖子;2、37℃培养箱中温育1小时至过夜;3、将浸染过的试材转入70%或95%乙醇中脱色2-3次(除去叶绿素),至阴性对照材料呈白色为止。
4、观察结果。
三、实验结果:转基因拟南芥野生型拟南芥(上)转基因拟南芥;(下)野生型拟南芥转基因拟南芥(作图上行从左数第一个的放大)四、分析讨论:1、预期结果:转基因植株被染成蓝色,野生型植株不被染色。
实际结果:与预期结果一致,但野生型脱色不完全,有几片叶子的叶绿素未被脱掉。
分析:实验较为成功。
由上图可知,转入的基因在整棵植株都有表达,其中蓝色在叶脉中最深,推测转入的基因在叶脉中表达最多。
在野生型植株中,大部分叶子被乙醇脱去叶绿素而呈现浅黄色。
2、gus基因是目前常用的一种报告基因,是β-D-葡萄糖苷酸酶(gus)基因,其表达产物β-葡萄糖苷酸酶(GUS)能催化裂解一系列的β-葡萄糖苷酸,它可以将5-溴-4-氯-3-吲哚-β-葡萄糖苷酸酯(X-Gluc)分解为蓝色的物质,也可以将4-甲基-伞形花酮-β-D-葡萄糖苷酯(4-MUG)分解为蓝色物质。
其检测方法简单、快速、灵敏、稳定,且背景活性低。
3、gus基因的最大优点是它能测定外源基因表达的具体细胞和组织部位,这是其它报告基因所不能及的。
4、gus基因是一种报告基因,报告基因是一种编码可被检测的蛋白质或酶的基因,也就是一个其表达产物非常容易被鉴定的基因。
把它的编码序列和基因表达调节序列相融合形成嵌合基因,或与其它目的基因相融合,在调控序列控制下进行表达,从而利用它的表达产物来标定目的基因的表达调控,筛选得到转化体。
报告基因是研究基因调控的有力工具,常用于判断试验基因的转化效率以及基因的调控与功能的研究实验中。
1.GUS报告基因的定性检测GUS能与显色底物X-gluc反应,显现蓝色,因而可以通过组织化学染色定性研究GUS的表达水平和表达模式。
GUS染色的稳定性好,组织定位精确,成为在植物中运用很广的报道基因。
1.1 GUS染色底物的配制按下表1配制GUS染色的底物。
表1. GUS染色底物的配制GUS 能与底物MUG(分子量352.3,4-甲基伞型酮-β-葡萄糖醛酸苷,4-methylumbelliferylβ-D-glucuronide)反应产生荧光物质MU(分子量198.2,4-甲基伞型酮,4-methylumbelliferone)。
MU的激发波长为365nm,发射波长为456nm,其含量可由荧光分光光度计测出。
因此,我们可以根据单位质量的植物总蛋白在单位时间内产生的荧光物质的多少来定量的检测GUS含量。
2.1 试剂配制1) 1mol/L Na2HPO4溶液:35.814g Na2HPO4溶于100ml水。
2) 1mol/L NaH2PO4 溶液:15.601g NaH2PO4 溶于100ml水。
3) 0.1M 磷酸缓冲液(PH7.0):1mol/L Na2HPO4取5.77ml,1mol/L NaH2PO4取4.23ml,定容至100ml。
4) 10% SDS溶液:将90ml水稍微加热,加10g SDS,搅拌溶解,加入几滴浓盐酸调节PH至7.2,然后加水定容至100ml。
5) 0.5 M EDTA (PH8.0):在80ml水中加入18.61g Na2EDTA•2H2O,用NaOH调PH至8.0(约需2g左右的固体NaOH),溶解后定容至100ml。
6) GUS酶提取液:0.1M 磷酸缓冲液(PH7.0)取50ml;10% SDS取1ml; 0.5MEDTA(PH8.0)取2ml;Triton X-100取100ul;β-巯基乙醇100ul;用水定容至100ml。
7) MUG底物:称8.8mg MUG,溶于10ml GUS酶提取液中,配制成2mmol/L的工作浓度。
GUS染色液的染色原理
GUS(β-Galactosidase)基因是存在于E.coli等一些细菌基因组内的编码β-葡萄糖苷酸酶的一种水解酶,该基因常作为融合标记用于植物转基因分析和调控研究中。
GUS染色的实验目的是对植物样本进行染色,因为绝大多数植物细胞内不存在内源GUS活性,因此GUS基因广泛用作转基因植物的报告基因。
GUS染色液是β-葡萄糖苷酶基因染色试剂盒(β-Galactosidase Reporter Gene Staining Kit)的简称。
GUS染色液染色原理是适宜的反应条件下,β-葡萄糖苷酶(GUS)可将X-Gluc水解成蓝色物质,该物质不溶解于转基因的细胞核组织中的靛蓝物质,具有GUS活性的部位或位点呈现蓝色或蓝色斑点,可用肉眼或显微镜观察到。
GUS染色液可用于生物化学活性分析、免疫分析以及组织和细胞的组织化学染色,多用于转基因植物的GUS基因表达分析。
该试剂仅用于科研领域,不适用于临床诊断或其他用途。
GUS染色液使用注意事项:
用于染色的植物材料的制备方法要因涉及的特定组织和器官的不同而异。
例如,拟南芥的根、花和叶片以及烟草幼苗的根就可以不作任何预处理而直接染色。
但是像烟草和马铃薯这些植物的茎和叶就必须在染色前切成薄片(1-
3mm)。
当操作大的组织和样品时,可以选用真空渗入法来帮助底物和酶渗入细胞。
精品资料欢迎下载。
GUS组织化学染色1. 实验原理适宜的反应条件下,β-葡聚糖苷酶(GUS)可将X-Gluc水解成蓝色物质,因此具有GUS活性的部位或位点呈现蓝色或蓝色斑点,可用肉眼或显微镜观察到。
2.实验材料1)转基因烟草叶片或试管苗2)非转基因烟草的叶片或试管苗(阴性对照)3.药品试剂1) X-Gluc,用N-N-二甲基酰胺配成20mM的贮存液,分装成每管100µL,保存于-20℃。
2) 底物溶液(染色液):3) 1mM X-Gluc加入100mM磷酸钠缓冲液(pH=7.0),缓冲液中含10mM ED TA-Na2,1-5mM K3[Fe(CN)6](铁氰化钾),1-5mM K4[Fe(CN)6](亚铁氰化钾),0.001%(V/V)Triton X-1004.实验器材小药瓶,培养皿,培养箱(37℃),微量移液器5.实验步骤1) 将准备好的叶片放入小药瓶,加入染色液浸没试材,封好盖子;2) 37℃培养箱中温育1小时至过夜;3) 将浸染过的试材转入70%或95%乙醇中脱色2-3次(除去叶绿素),至阴性对照材料呈白色为止。
6.结果叶片上GUS活性的部位或位点呈现蓝色或蓝色斑点。
先用DMSO溶解X-GLUC 好像是100mg/2ml PBF 94ML+X-GLUC 0.1ML+TRIT ION X-100 2ML +FE2+ 2ML+ FE3+ 2ML/plsc/labs/sherrierlab/Methods_pdf/microscopy/Protocol%2 0for%20Fluorescent%20GUS%20Staining%20of%20Root%20Nodules.pdf /stockingerlab/Protocols/GUS-HistochemicalS taining.pdf/langdalelab/protocols/misc/Dex_induc_GUS_stain.p dfGus staining1. Excise root and leaf segments, wash with 100mM potassium phosphate buffer (pH7.0) for 3 times.2. Immerse in the Gus substrate solution, 37C, dark, 12-24h3. Rinse in phosphate buffer4. Fix for 4h or longer5. Rinse in the same buffer6. Observe as whole specimens or as sections.1M potassium phosphate buffer (pH7.0)K2HPO4: 34.8g --->200mlKH2PO4: 27.2g---->200ml184.5ml K2HPO4+115.5ml KH2PO4----> 300ml 1M potassium phosphate b uffer(pH7.0)Gus substrate solutionVolume(500ml)Final concentrationPotassium ferricyanide82mg0.5mMPotassium ferrocyanide105.6mg0.5mMPotassium phosphate buffer (pH7.0, 1M)50ml100mMStore at -20C. Add 1mM x-gulc (MW521.8~~0.5mg/ml) freshly when use. Fix solution2.5% glutaraldehyde200mM sodium cacodylate, pH7.2共培养后愈伤的瞬时表达、抗性愈伤的鉴定以及转基因植株的鉴定用GUS组织化学法测定.将待测定的材料,如愈伤或叶片,浸入适量X-Gluc溶液,于37 ℃保温过夜后,在体视显微镜下观察,拍照记录.若将加有X-Gluc溶液的材料抽真空,染色效果将更好.如材料存在色素干扰问题,染色后用酒精脱色,使色素的颜色褪掉而使染成的蓝色保存.X-Gluc染色液:(20*)0.2mol/L Na3PO4缓冲液(62mL0.2mol/L Na2HPO4;38mL0.2 mol/L NaH2PO4),pH7.0;0.1 mol/L K3[Fe(CN)6];0.1 mol/L K4[Fe(CN)6].3H2O;1.0 mol/L Na2EPTA;0.1% X-Gluc.1000mlx-gluc 1000mg (20ml dmso)Na2HPO4: 620*0.2*M=0.620*0.2*358(12H2O)=44NaH2PO4: 380*0.2*M=0.358*0.2*156(2H2O)=11K3[Fe(CN)6:1000*0.01*M=329.26*0.01=3.3K4[Fe(CN)6]:1000*0.01*M=422.39(3H2O)*0.01=4.2Triton 1MLNa2EPTA:1000*0.1*M=372.24(2H2O)=371. 取5 mg X-Gluc (5-bromo-4-chloro-3-indolyl glucuronide)溶於100 l DMSO於中.2. 加入10 ml reaction buffer (10 mM Na2EDTA, 100 mM NaH2PO4·H2O, 0.1% Triton, 0.5 mM potassium ferricyanide, 0.5 mM potassium ferrocyanide, pH7.0).3. 混合均匀后分装於eppendorf tube中,保存於-20℃冰箱内.100ml x-gluc染液配制x-gluc 50mg加入溶入1ml dmso1ml triton 100Na2EDTA (20mM) 10mM 5ml ; K3Fe(CN)6 (0.1M) 5mM 0.5mlK4Fe(CN)6 (0.1M) 5mM 0.5ml ; Na2HPO4 (0.2M) 100mM 3.1mlNaH2PO4 (0.2M) 100mM 1.9mlX-Gluc 0.1% 10ul。